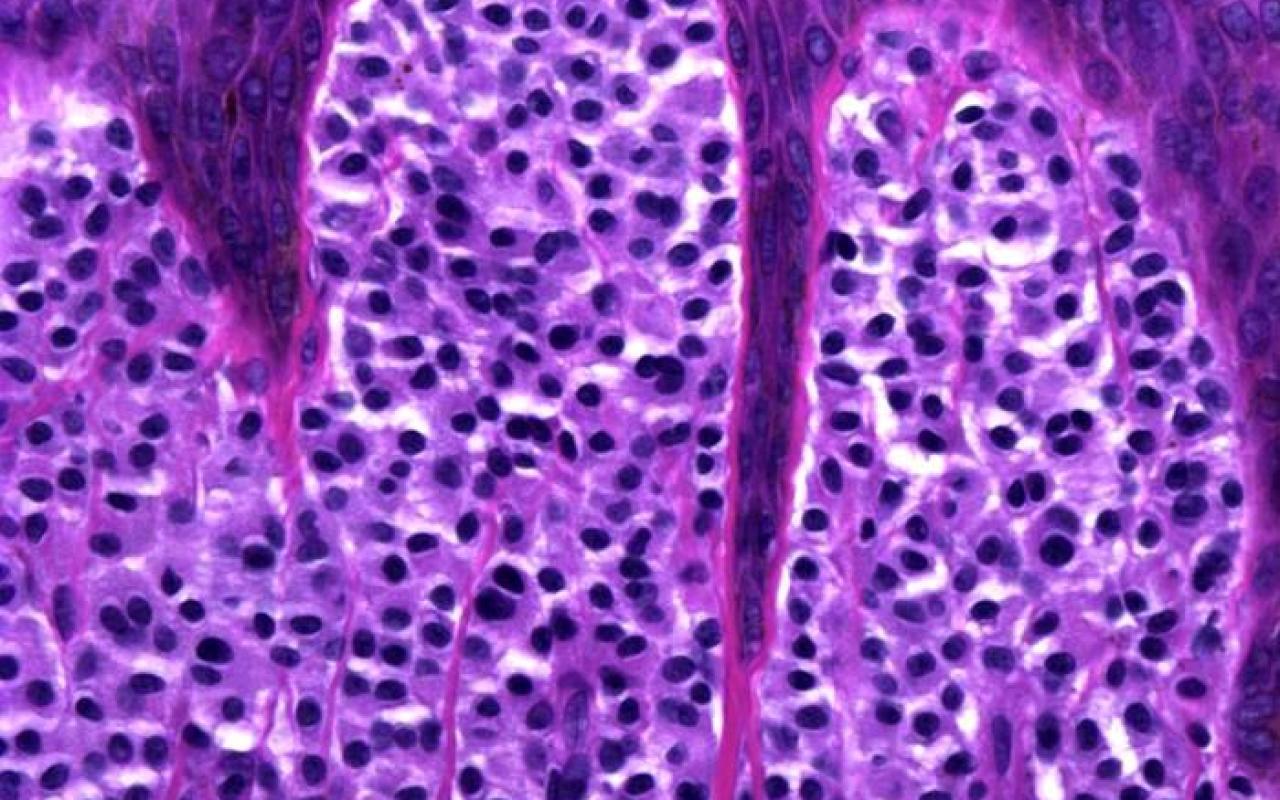

- This neoplasm derives from which structure?
A-Apocrine gland
B-Hair follicle
C-Eccrine duct
D-Subcutaneous fat E-Muscle

Correct choice: A. Apocrine gland
Explanation: Adenoid cystic carcinoma is considered a malignant apocrine tumor. It appears most commonly in the oral cavity and has a very unpredictable course.
- If positive, which immunohistochemical stain supports further evaluation with colonoscopy and cystoscopy?
A. CK20
B. Congo Red
C. S100
D. CD34
E. Neuron specific enolase

Correct choice: A. CK20
Explanation: Extramammary Paget’s Disease is an intraepithelial adenocarcinoma of apocrine glands that presents with a well-demarcated erythematous plaque in the genital area. Histologically, pagetoid cells stain positive for CK7, unlike pagetoid melanoma cells which stain positive for S100. CK20 staining has been associated with secondary EMP in the setting of underlying gastrointestinal or genitourinary carcinoma.

- A 60-year-old man presents with a poorly demarcated, symmetric, very painful patches of erythema and retiform purpura favoring the buttocks. Bullae and a dusky gray discoloration developed and ulcerations appeared with a black, leathery eschar. Upon palpation there is a surrounding subcutaneous induration that extends beyond the margins of the visibly active lesions. You perform a skin biopsy (see image). Which of the following is the most likely diagnosis?
A. Calciphylaxis
B. Cryoglobulinemia
C. Protein C deficiency
D. Warfarin necrosis
E. Subcutaneous fat necrosis

Correct choice: A. Calciphylaxis
Explanation: calciphylaxis is characterized by intimal fibrosis and medial vascular calcification (that can become transmural) as well as transdifferentiation of vascular smooth muscle cells into osteoblast-like cells; these changes plus thrombosis lead to ischemic necrosis of the skin and soft tissues. Early lesions usually present as poorly demarcated, often symmetric, very painful patches of erythema or retiform purpura. They favor areas with abundant adipose tissue or sites of trauma. Bullae or a dusky gray color may then develop, signifying imminent tissue necrosis and the appearance of ulcerations with black, leathery eschars. Often there is surrounding subcutaneous induration that extends beyond the margins of the visibly active lesions and this can be helpful in distinguishing calciphylaxis from other forms of retiform purpura.
2- Cryoglobulins cause disease via two mechanisms: occlusion (type I) or immune complex- mediated vasculitis (types II, III). Simple occlusion with minimal early inflammation and often retiform purpura/necrosis develops when cryoproteins precipitate upon cold exposure, and this is primarily a reflection of monoclonal immunoglobulins (IgG, IgM ≫ IgA, light chains), i.e. type I cryoglobulinemia that is due to an underlying plasma cell dyscrasia or lymphoproliferative disorder.
Immune complex disease leads to inflammatory purpura that is palpable, and this is related to mixed cryoglobulinemia (types II or III), often due to hepatitis C viral infection.
3- In contrast, homozygous (or compound heterozygous) deficiency or severe dysfunction of either protein C or protein S leads to neonatal purpura fulminans within a few hours to 5 days after birth, and it is fatal unless treated.
4- In warfarin necrosis, the procoagulant system takes significantly longer to reach its low-point equilibrium than does the protein C-dependent anticoagulant activity. Warfarin necrosis usually develops within 2–5 days of starting warfarin in the absence of heparin, and it is much more likely to occur if loading doses of warfarin are used. A history of warfarin therapy is not mentioned in the clinical stem.
5- Subcutaneous fat necrosis is the development of one or more mobile, firm, subcutaneous nodules or plaques during the newborn period. It is sometimes associated with hypercalcemia or thrombocytopenia. Histology is characterized by granulomatous lobular panniculitis with needle- shaped clefts within lipocytes and giant cells.
- What medication causes the following lesion to erupt?
A. Metformin
B. coumadin
C. ace inhibitors
D. Indinavir
E. azathioprine

Correct choice: D. Indinavir
Explanation: Indinavir, capecitabine, systemic retinoids, hydroxyurea and GMCSF cause pyogenic granulomas to erupt.

- This rash is characterized histologically by what finding?
A. Wedge-shaped infiltrate with large cells within the infiltrate
B. Lichenoid infiltrate
C. Acanthosis and neutrophilic aggregates in the epidermis
D. Mounds of parakeratosis
E. Irregular acanthosis

Correct choice:D. Mounds of parakeratosis
Explanation: This is pitryriasis rosea which is characterized by mounds of parakeratosis histologically.
- The following clinical manifestation is most commonly seen in the setting of:
A- liver failure
B- renal failure
C- thyroid disease
D- a genetic disorder
E- obesity

Correct choice: B. renal failure
Explanation: Calciphylaxis (calcific uremic arteriolopathy): ulcers with black eschars, violaceous reticulated plaques on proximal limbs of patients with end-stage renal disease, often with hyperparathyroidism, sometimes resulting in death, calcification in small- to medium-sized blood vessels in dermis and fat, with secondary thrombosis, panniculitis, and fat necrosis.
- Immunohistochemical staining with neuron-specific enolase is positive in:
A. Anaplastic large cell lymphoma
B. Malignant firbroushistiocytoma
C. Cutaneous T cell lymphoma
D. Merkel cell carcinoma
E. Sebaceous carcinoma
Correct choice: D. Merkel cell carcinoma
Explanation: Neuron-specific enolase (NSE) is a cytoplasmic product produced by Schwann cells and neurons. This enzyme is present in neuroendocrine cells, neurons and tumors derived from them. Positive staining for NSE is found in Merkel cell carcinomas, carcinoid tumors, and malignant melanoma (among others). The remaining answer choices show negative staining with NSE.
- This lesion is characterized by dermal deposition of which material?
A. Amyloid
B. Mucin
C. Fibrin
D. Uric acid
E. Lipid

Correct choice: D. Uric acid
Explanation: Gouty tophi are formed by the deposition of monosodium urate crystals. Fibrin is found in rheumatoid nodules, and mucin is deposited in lesions of granuloma annulare.
- On histology of a eccrine ductal carcinoma there are ducts and nest of epithelial cells associated with a dense fibrous stroma. There is variable nuclear pleomorphism, mitotic activity, and are positive for CK7 and also:
A. Estrogen and progesterone receptor positive
B. CK20 positive
C. Oil red O
D. p53 positive
E. Keratin positive
Correct choice: A. Estrogen and progesterone receptor positive
Explanation: In an eccrine ductal carcinoma, the estrogen and progesterone receptor can be positive. They are often positive for CK7, CEA, negative CK20, S100 and GCDFP-15 positive.
- What is this condition?
A. Gouty Tophus
B. Sarcoid
C. Keratin granuloma
D. Rheumatoid Nodule
E. Granuloma annulare

Correct choice: A. Gouty Tophus
Explanation: Gouty Tophi occur due to an accumulation of monosodium urate in the tissues. Deposits in the dermis act as a foreign body and granulomas form around these deposits. Unless the tissue is fixed with alcohol (Carnoy’s fixative), the yellow brown crystals of gout are not well visualized on H and E. When the tissue is submitted in formalin the tophus appears pink and amorphous.Gout is diagnosed in the initial attack by using a needle and syringe to extract a small sample of fluid from around the affected joint space. MSU crystals can be identified under the microscope. This test is also important to rule out other causes of an inflamed joint, such as infection. If a biopsy sample is taken, the specimen should be placed in alcohol, as formalin dissolves urate crystals. Joint x-rays may show findings consistent with gout, but these findings are not diagnostic on their own. Furthermore, early on in the disease, x-rays may be normal or show soft tissue swelling only. Urate levels may be elevated in the blood, but this finding alone is not diagnostic. In some cases, the level may even be below urate saturation.
- Positive staining with Gross cystic disease fluid protein 15 (GCDFP-15) suggests:
A. An apocrine origin
B. An eccrine origin
C. A sebaceous origin
D. A follicular origin
E. A keratinocyte origin
Correct choice: A. An apocrine origin
Explanation: Gross cystic disease fluid protein-15 (GCDFP-15) is a commonly used apocrine marker. Gross cystic disease fluid protein-15 (GCDFP-15) is not a marker of the remaining answer choices.
- The best diagnosis is:
A. Schwannoma
B. Neurofibroma
C. Pallisaded and encapsulated neuroma
D. Perineurioma

Correct choice:C. Pallisaded and encapsulated neuroma Explanation: Pallisaded and encapsulated neuroma
- What is your best diagnosis?
A. Sebaceous Glands
B. Sebaceum
C. Lichen Planus
D. Atopic Eczema
E. Angiofibroma

Correct choice:E. Angiofibroma
Explanation: Angiofibroma is a small reddish spot or bump that consists of fibrous tissue and blood vessels. They are most commonly found around the nose, cheeks, and chin, often combining to form a distinctive butterfly-shaped pattern. Previously known as adenoma sebaceum.
- What immunohistochemical stain is most likely to be positive in this condition?
A. HPV
B. HHV-8
C. PAS
D. S100
E. Tryptase

Correct choice: E. Tryptase
Explanation: The figure illustrates lesions of urticaria pigmentosa, which stain positively for tryptase or c-kit as well as Giemsa, Leder, or toluidine blue. Patients typically present with red- brown macules or slightly raised papules which may demonstrate a positive Darier’s sign (urticaration with rubbing). HPV stain is positive in verrucae, HHV-8 is positive in Kaposi Sarcoma, PAS is positive in a variety of conditions and is helpful in visualizing dermatophytes in the epidermis, and S100 is found in a variety of conditions including melanoma.
- Which of the following is the most likely diagnosis of this image?
A. Lipoma
B. Merkel cell carcinoma
C. Metastatic adenocarcinoma
D. Melanoma
E. Myxoid neurothekeoma

Correct choice:C. Metastatic adenocarcinoma
Explanation: In this image, the lymphatics are filled with large atypical cells trying to form glands making metastatic adenocarcionma the most likely diagnosis. Merkel cell carcinoma is a sheet of blue cells with salt and pepper nuclei. A lipoma is a collection of normal fat. Melanoma would have nests of atypical melanocytes. A myxoid neurothekeoma would be a loose collection of cells in thekes with a cellular stroma and the cells do not attempt to form glands.
- What is this neoplasm?
A. Mastocytoma
B. Poroma
C. Glomus tumor
D. Langerhans cell histocytosis
E. Nevus
Correct choice:E. Mastocytoma
Explanation: Approximately 10% cases of mastocytosis present as a solitary lesion, otherwise known as a mastocytoma. Typically they present in childhood on trunk or wrist and usually are self limited and spontaneously resolve. Histologically the epidermis overlying the mast cell proliferation is often hyperpigmented. Within the dermis there are increased numbers of “fried egg” mast cells. Often the mast cells are primarily located in the upper dermis where they fill and expand the dermal papillae. Frequently admixed among the mast cells there are increased numbers of eosinophils.
- A male patient presents with hypopigmented macules on his upper back that are asymptomatic and more noticeable in the summer. What is the most likely diagnosis?
A. pityriasis rosea
B. vitiligo
C. tinea versicolor
D. eczema
E. waardenberg syndrome

Correct choice:C. tinea versicolor
Explanation: Tinea versicolor often is asymptomatic and more noticeable in the summer as patients often tan and the areas with the tinea versicolor do not tan as azeleic acid is secreted by the malassezia and melanin production is suppressed.
- On histology, this type of dermatofibrosarcoma protuberans is associated with recurrence and is regarded as a poor prognosis. It is characterized by a typical herringbone morphology of more closely packed spindled cells with increased mitosis. This best describes:
A. Bednar tumor
B. Fibrosarcomatous tumor
C. Giant cell fibroblastoma
D. Fibroblastic tumor
E. Angiodermatofibrosarcoma tumor
Correct choice: B. Fibrosarcomatous tumor
Explanation: This best describes the fibrosarcomatous type of dermatofibrosarcoma protuberans. It has a high rate of recurrence and is associated with a poor prognosis. They are also CD34+ and wide excision is recommended.
- Cellular neurothekeoma stains with:
A. Stromelysin-3
B. Desmin
C. S-100
D. PGP-9.5
E. Low molecular weight keratin
Correct choice: D. PGP-9.5
Explanation: PGP-9.5 and S100-a6 stains cellular neurothekeoma. Stromelysin-3 is positive in dermatofibromas and negative in dermatofibrosarcoma protuberans. Desmin stains rhabdomyosarcoma. S-100 stains neural tumors and melanocytic tumors among other things, but cellular neurothekeomas are generally S100-negative.
- What is the best diagnosis for this vesiculobullous disorder?
A. Bullous Pemphigoid
B. Porphyria Cutanea Tarda
C. Pemphigus vulgaris
D. Dermatitis Herpetiformis
E. Arthropod Bite

Correct choice:A. Bullous Pemphigoid
Explanation: Bullous Pemphigoid: Most common subepidermal blistering disease that frequently occurs on abdomen, groin, flexor surface of arms and legs of the elderly. In men an association with HLA-DQ7 has been seen. Often eosinophilia and elevated IgE is seen in the serum. The pathogenesis of this blistering disorder is due to binding of antibodies, IgG1 and 4 or IgE and rarely IgA, to BPAg I (230kd) and/or BP Ag II (180kd) in the hemidesmosome. Histologically there is a unilocular subepidermal blister with eosinophils. Early lesions may show eosinophilic spongiosis with papillary dermal edema. Within the dermis there is a lymphocytic eosinophilic infiltrate that is both perivascular and interstitial. DIF shows linear deposits of C3> IgG along the DEJ. Salt split skin show localization of immunoreactants in the vesicle roof. Circulating anti-BMZ antibodies are seen in 60-80% of patients but do not correlate to disease activity.
- The PDGF gene has been shown to be translocated into the collagen I gene in:
A. Angiofibroma
B. Dermatofibroma
C. Dermatofibrosarcoma protuberans
D. Fibrous hamartoma of infancy
E. Solitary fibrous tumor
Correct choice:C. Dermatofibrosarcoma protuberans
Explanation: A translocation involving the PDGF gene and collagen I gene is found in dermatofibrosarcoma protuberans.
- Which disease process best describes Texier’s disease?
A. Neutrophilic dermatosis
B. Deposition disorder
C. Infectious process
D. Panniculitis
E. Granulomatous disease
Correct choice:D. Panniculitis
Explanation: Texier’s disease is a panniculitis secondary to vitamin K injections causing sclerotic lesions with lilac borders on the buttocks and thighs resembling a cowboy belt and holster. Inflamed nodules with varying degrees of pain and fibrosis have been observed in other forms of panniculitis due to injection, with the distribution of lesions sometimes providing a clue to their cause. A dramatic example of this is Texier disease, a panniculitis due to phytonadione (vitamin K) injections. In this disorder, sclerotic lesions with lilac-colored borders form on the buttocks and thighs, in aconfiguration resembling a “cowboy gunbelt and holster”. Lesions due to blunt trauma often have an ecchymotic character andinvolve locations such as the shin, arm or hand. Hypertrichosis may also be present, possibly the consequence of local hyperemia or angiogenesis.
- What is the most likely diagnosis?
A. Wood splinter
B. suture
C. silicone
D. gel foam
E. Hyaluronic acid

Correct choice:A. Wood splinter
Explanation: Wood splinter is brown with rectangular cells. Suture is typcially a circle filled with many smaller circles. Silicone is a collection of vacoules. Gel foam is an irregularly shaped purple mass. Hyaluronic acids are just like mucin wispy and purple collections.
- This disorder is sometimes asscociated with what other symptoms?
A. Fissured tongue and facial nerve palsy
B. Shortness of breath
C. Angiomas
D. Atopic dermatitis
E. Neuroma

Correct choice:A. Fissured tongue and facial nerve palsy
Explanation: Melkersson-Rosenthal syndrome is traditionally characterized by the triad of granulomatous cheilitis, facial nerve palsy, and fissured tongue.









































































































































































